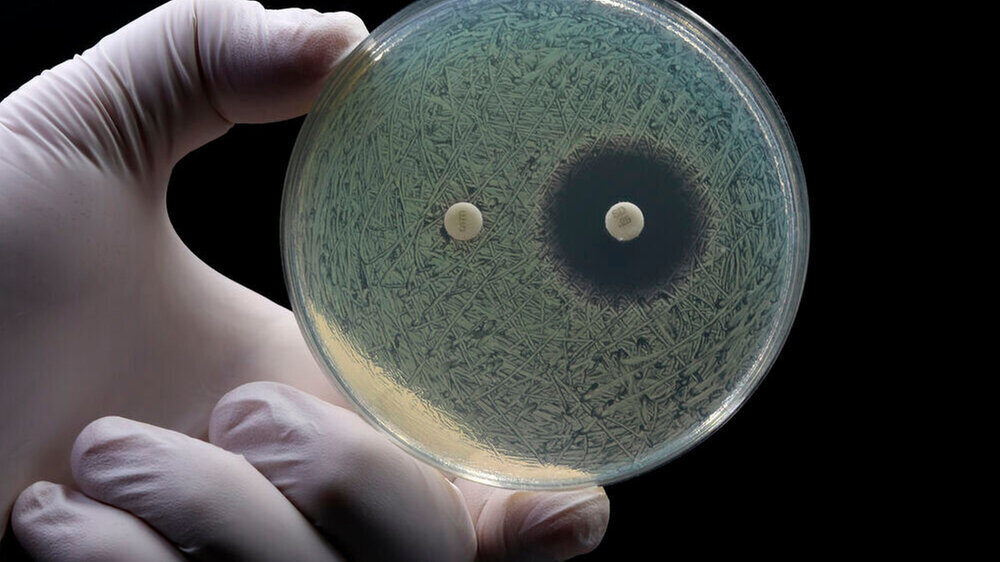

„Wir brauchen ein standardisiertes Delabeling von Antibiotikaallergien“
Das seit vielen Jahren beobachtete Phänomen bewirke, „dass Patient:innen von der Anwendung von Standard-Antibiotika ausgeschlossen werden, was zum Ausweichen auf Reserve-Antibiotika führt", heißt es in einem Positionspapier der Deutschen Gesellschaft Pädiatrische Infektiologie (DGPI), der Gesellschaft für Pädiatrische Allergologie und Umweltmedizin (GPA) und dem Berufsverband der Kinder- und Jugendärzt*innen (BVKJ). Das Label einer „Antibiotikaallergie“ schränke den Einsatz spezifisch wirksamer Antibiotika ein und trage so zur Resistenzdynamik bei.
„Die ungesicherte Annahme einer Penicillinallergie kann dazu führen, dass Patient:innen von der leitliniengerechten Anwendung von Betalaktamantibiotika ausgeschlossen werden und so Zweit- oder Drittlinientherapien zur Anwendung kommen“, führen die Fachgesellschaften weiter aus. „Die vermeintliche Diagnose einer Antibiotikaallergie führt häufig zum unnötigen Einsatz von Reservetherapien mit potenziell schlechteren klinischen Ergebnissen.“ Von den zehn Prozent der als Penicillin-allergisch gekennzeichneten Patient:innen hat die Mehrheit einer Studie zufolge nie eine echte allergische Reaktion erlebt, sondern andere unerwünschte Reaktionen wie Magen-Darm-Beschwerden [Brockow et al. 2025].
„Voreilige Diagnosen schaden der Bevölkerungsgesundheit“
Das Label einer Penicillinallergie sei verschiedenen Studien zufolge mit einer längeren Krankenhausverweildauer, höheren Behandlungskosten und schlechterem klinischen Outcome assoziiert. Für Kinder mit Pneumonie gehe dies darüber hinaus auch mit einem höheren Risiko von respiratorischem Versagen und der Notwendigkeit einer intensivmedizinischen Behandlung einher.
„Daher ist es für die Patient:innen entscheidend, dass voreilige Diagnosen einer Betalaktamallergie aufgrund von anfänglichen Verdachtsmomenten nicht erfolgen und im Nachgang die Möglichkeit besteht, die Diagnose einer Betalaktamallergie überprüfen zu lassen und gegebenfalls auszuschließen (Delabeling), um wieder für gezielte antibiotische Erstlinientherapie infrage zu kommen. Es ist darüber hinaus auch unter den Gesichtspunkten Bevölkerungsgesundheit und Gesundheitsökonomie geboten.“
„Ein standardisiertes Delabeling ist nicht ausreichend finanziert“
Um den Einsatz von Zweitlinientherapien zu vermindern, sei ein standardisiertes „Delabeling“ von angenommenen Antibiotikaallergien erforderlich, schreiben DGPI, GPA und BVKJ. „Das Delabeling von Antibiotikaallergien erfolgt nach einem standardisierten, risikostratifizierten Vorgehen, das je nach Reaktionstyp (Soforttyp oder Spättyp) und Schweregrad der ursprünglichen Reaktion unterschiedlich gestaltet wird. [...] Die praktische Umsetzung umfasst eine gründliche Allergieanamnese, Patienteneinwilligung, überwachte Testdurchführung, Dokumentation und Patientenaufklärung. Diese Strategien verbessern nicht nur die individuelle Versorgung, sondern fördern auch den rationalen Antibiotikaeinsatz im Rahmen des Antibiotic Stewardship.“
Um ein systematisches Vorgehen in die breite Anwendung zu bringen, sei jedoch die Sicherung einer suffizienten Finanzierung des Delabelings in der ambulanten Versorgung eine politische Notwendigkeit, argumentieren die Unterzeichner. „Die aktuelle Vergütungssituation berücksichtigt weder den erheblichen Zeitaufwand für die qualifizierte Anamnese, die mehrstündige Überwachung und die notwendige Nachsorge, noch die Vorhaltekosten für Notfallequipment und qualifiziertes Personal.“
Angesichts der erheblichen gesundheitsökonomischen Vorteile eines erfolgreichen Delabelings – Reduktion von Reservetherapien, Verkürzung von Krankenhausaufenthalten, Verminderung von Komplikationen und Resistenzentwicklungen – sei eine angemessene Vergütung dieser medizinischen Maßnahme dringend erforderlich und volkswirtschaftlich sinnvoll.
Brockow K, Pfützner W, Wedi B, Wurpts G, Trautmann A, Kreft B, et al. Recommendations on how to proceed in case of suspected allergy to penicillin/β-lactam antibiotics. Allergol Select 2025;9:28–39. https://doi.org/10.5414/ALX02531E.